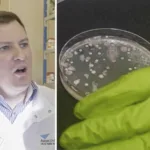

James May har ägt två egna elbilar och ser fördelar med konceptet. Samtidigt känner han sig starkt skeptisk mot elbilen som produkt idag.
– Ambitionsnivån är högre än vad teknologin erbjuder. Teknologin är inte tillräckligt bra idag, säger Top Gear-profilen.
Det var podden The Intercooler som James May gästade och uttryckte sina tveksamheter om elbilar. Han har själv ägt två olika Teslor och ett flertal vätebränslecell-Toyotas, men han känner sig fortfarande kluven till elbilar.
Ett av argumenten han lyfter mot elbilar som koncept är laddningen. Han tycker att det både tar för lång tid att ladda och att det finns alldeles för få laddstationer. Förutom att köa måste du vid längre resor planera körningen efter laddstationer. Inte den snabbaste vägen, hävdar Top Gear-profilen.
– Jag är en dålig ambassadör för elbilar, säger James May.
Även om han uttrycker sig skeptiskt mot elbilar ser han fortfarande fördelar som andra bilar inte kan ge. Bland annat tystnaden under körningen.
– Tystnaden känns som Star Trek för mig. Elbilarna är så snälla. Om jag är ute och kör klockan fyra på morgonen stör jag inte ens maskarna i marken.
James May säger i podcasten att han är positiv mot elbilen och ser den som framtiden för bilar. Top Gear-profilen tycker konceptet med att den sällan behöver ses över och ger ifrån sig noll avgaser är fullt rimligt. Problemet elbilen alltid haft är el-kapaciteten menar han.
– Om elbilar hade haft mindre batterier och kunnat ladda snabbare hade jag älskat det.
Han fortsätter sedan argumentera för att elbilars batterier idag är enorma för att de ska kunna ha längre räckvidd. Samtidigt kommer de inte att kunna slå en diesel- eller bensinbil inom den kategorin. Iallafall inte i nuläget, säger TV-profilen.
– Jag gillar att vara en del i experimentet med elbilar, som en bilfantast ser jag det nästan som obligatoriskt.
LÄS MER:

William Karlsson är examinerad journalist och har bland annat arbetat på Sveriges Radio och Sörmlands Nyheter.